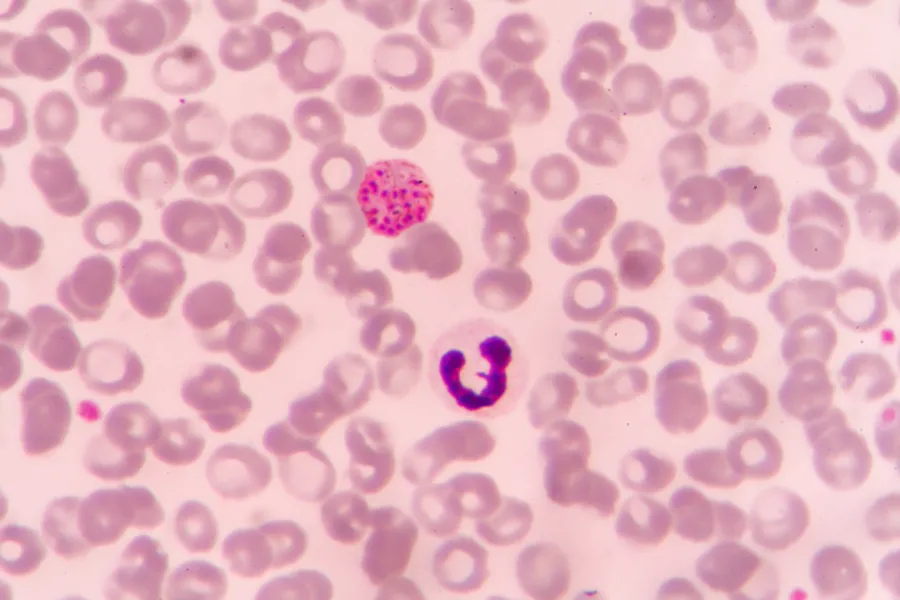
A microscopic view of malaria parasite P. vivax

ANNAPOLIS, MD. – Radical solutions to climate change might save lives, but a commentary in the October 2018 issue of the journal Nature Climate Change calls for caution because geoengineering still lacks a “clean bill of health.”
With global fossil-fuel emissions reaching an all-time high and the United States’ withdrawal from the Paris Agreement, climate experts have become increasingly interested in “climate engineering,” a set of ambitious and largely undeveloped technologies that could artificially counteract global warming. One proposed approach, called solar radiation management (SRM), would reduce incoming sunlight by injecting tiny aerosol particles into the stratosphere or by brightening clouds. Other approaches would directly remove carbon dioxide from the atmosphere.
Even if some combination of these worked, scientists warn that the climate wouldn’t be the same as it was before climate change. And those differences might make a big difference for global health, ecologists Colin Carlson and Christopher Trisos argue in the Nature Climate Change article. The article was written while both were postdoctoral fellows at the National Socio-environmental Synthesis Center (SESYNC), a unique University of Maryland center funded by the National Science Foundation that brings together science of the natural world with science of human behavior and decision-making.
So far, Carlson and Trisos say, almost nothing is known about the potential health consequences of such geoengineered “solutions.”
“We’re a step before saying these technologies will probably save lives or saying they’re too dangerous to use,” says Carlson. “Right now, what we know is climate and disease are already closely linked, and that raises basic questions about climate engineering. Now, we need answers.”
Carlson gives the example of malaria, a disease mostly confined to the tropics today, but was once widespread in Europe and North America. Recently, scientists found that malaria transmits best at cooler temperatures. In some projections, SRM would disproportionately cool off the tropics—and that might make malaria worse.
“But it’s all guesswork—we can qualitatively talk through possible risks, and that’s what we do here. But we can’t make any judgements without solid, quantitative evidence. And no one’s run those models yet. There’s no data to go off.”
Carlson and Trisos hope to shed some light on these issues over the next two years. They are part of an international, interdisciplinary team that has been recommended for a $50,000 grant from the DECIMALS Fund (Developing Country Impact Modelling Analysis for SRM), which was launched by the Solar Radiation Management Governance Initiative to help scientists understand how SRM could affect the “global south”—a term that refers to less developed countries. Eight projects will receive DECIMALS grants that will be announced in October. The fund is administered by The World Academy of Sciences.
“Links between climate change and health are often complex, so climate engineering may impact health in unexpected ways,” says Trisos, now a research affiliate at the African Climate and Development Initiative. “Governments have pledged to prevent ‘dangerous anthropogenic interference’ with the climate system, so it’s critical that we can compare public health risks from climate change to those from climate engineering, in order to decide if climate engineering should even be considered.”
Carlson and Trisos’ DECIMALS research proposal was put together in collaboration with lead researchers Shafiul Alam and Mofizur Rahman (International Centre for Diarrhoeal Disease Research in Bangladesh) and includes epidemiologist Shweta Bansal (Georgetown University), climatologist Alan Robock (Rutgers University), and world-renowned microbiologist and cholera expert Rita Colwell (University of Maryland, formerly the ninth director of the National Science Foundation).
Their team is designed to produce important results on a fast deadline.
“Climate scientists, ecologists and public health researchers are increasingly working together to understand what climate change means for infectious diseases,” says Trisos. “We’re lucky to take advantage of that partnership to tackle a problem this complicated—and this urgent.”
In a perfect world, understanding the possible health impacts of climate engineering might help policymakers make the right call, if other options seem limited. But Carlson says there’s another reason this work is important.
“From a public health standpoint, we’re not likely to be the ones making the call about climate futures. But we want to know what’s coming if climate engineering does happen, and we want to be prepared, first in places like Bangladesh that might have the most to gain but also have the most to lose.”
Bangladesh is the world’s hot spot for cholera and has led the global research program to prevent the disease for several decades, with medical care reducing fatalities from 50 percent to less than 5 percent. Climate change will only increase the pressure that countries like Bangladesh face from infectious diseases like cholera and malaria.
“Whether or not the climate engineering ‘button’ gets pushed, the research we do here still helps us,” Carlson explains. “We’re building our toolbox and getting better at predicting cholera and malaria, and that should save lives, whatever climate change looks like.”